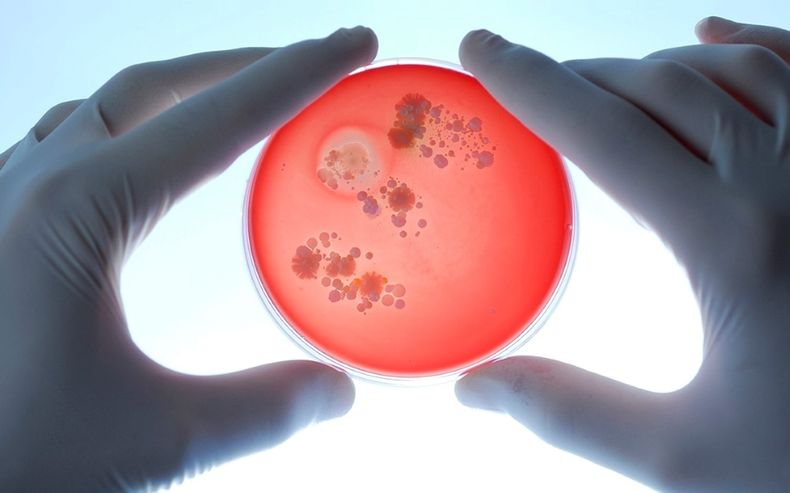
microbioma intestinal.jpg

El éxito o fracaso a la hora de adelgazar está determinado en gran medida por la microbiota intestinal, un hallazgo que servirá para hacer pruebas diagnósticas e identificar a las personas que tienen más probabilidades de perder peso con un estilo de vida saludable y a las que podrían necesitar intervenciones más drásticas.
El estudio, liderado por el Instituto de Biología de Sistemas de Seattle, Washington (EE.UU.), se publicó esta semana en Systems, una revista de la Sociedad Americana de Microbiología.
"El microbioma intestinal puede ayudar o causar resistencia a la pérdida de peso y esto abre la posibilidad de intentar alterar el microbioma intestinal para influir en la pérdida de peso", resume el autor principal del estudio, el doctor Christian Diener, científico del Instituto de Biología de Sistemas de Seattle.
Para hacer la investigación, Diener y su equipo analizaron el estilo de vida de 105 personas, pero, en lugar de imponerles una dieta específica o un programa de ejercicios, la intervención consistió en un programa de entrenamiento conductual.
Durante el año que duró el estudio, 48 individuos lograron una pérdida de peso constante y una mejora de los marcadores de salud metabólica y 57 mantuvieron su peso estable.
Genes de quienes adelgazan ayudan a las bacterias a crecer más rápido
Posteriormente, los investigadores estudiaron la metagenómica -material genético recuperado de muestras de sangre y heces- y los metabolitos de la sangre, las proteínas sanguíneas, los análisis clínicos, los cuestionarios dietéticos y las bacterias intestinales de los dos grupos.
Entre otras cosas, observaron que en los microbiomas de los que adelgazaron, los genes que ayudan a las bacterias a crecer más rápido, multiplicarse y replicarse se incrementaban, mientras que en las personas que no bajaron peso, la capacidad del microbioma intestinal para descomponer almidones aumentó.
"Antes de este estudio, sabíamos que la composición de las bacterias en el intestino era diferente en las personas obesas que en las no obesas, pero ahora hemos visto que hay un conjunto diferente de genes codificados en las bacterias de nuestro intestino que también responde a las intervenciones de pérdida de peso", apunta Diener.
Por tanto, "el microbioma intestinal es un factor importante que modula el éxito o no de una intervención para perder peso. Los factores que dictan la obesidad frente a la no obesidad no son los mismos que dictan si se perderá peso con una intervención de estilo de vida", concluye.
MIRA ACÁ UN NUEVO VIDEO DE “LA KALLE SABE”